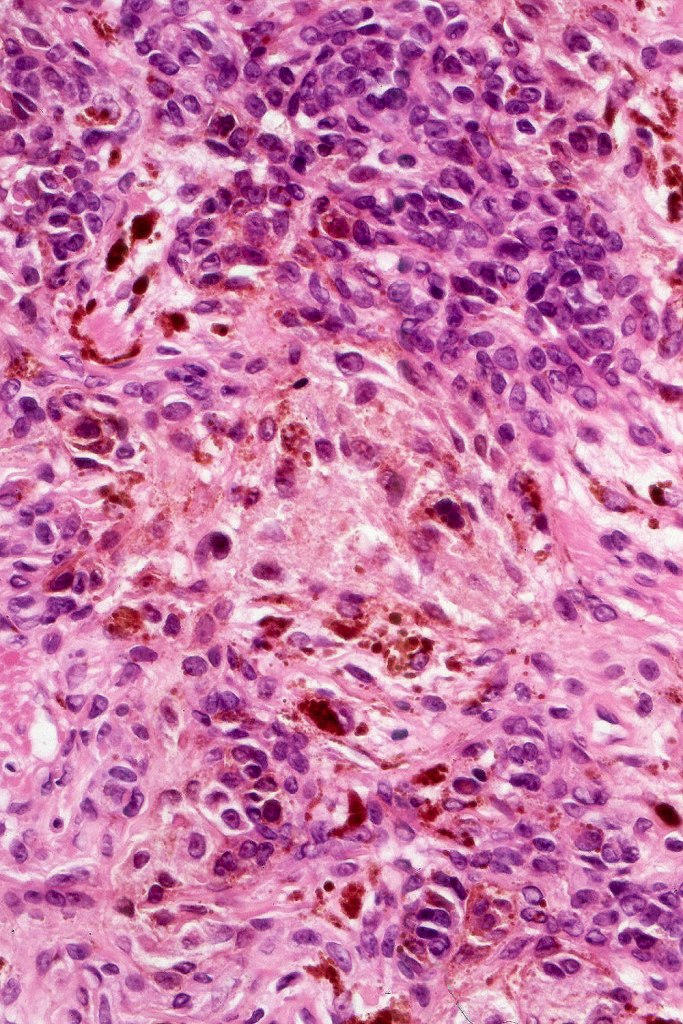
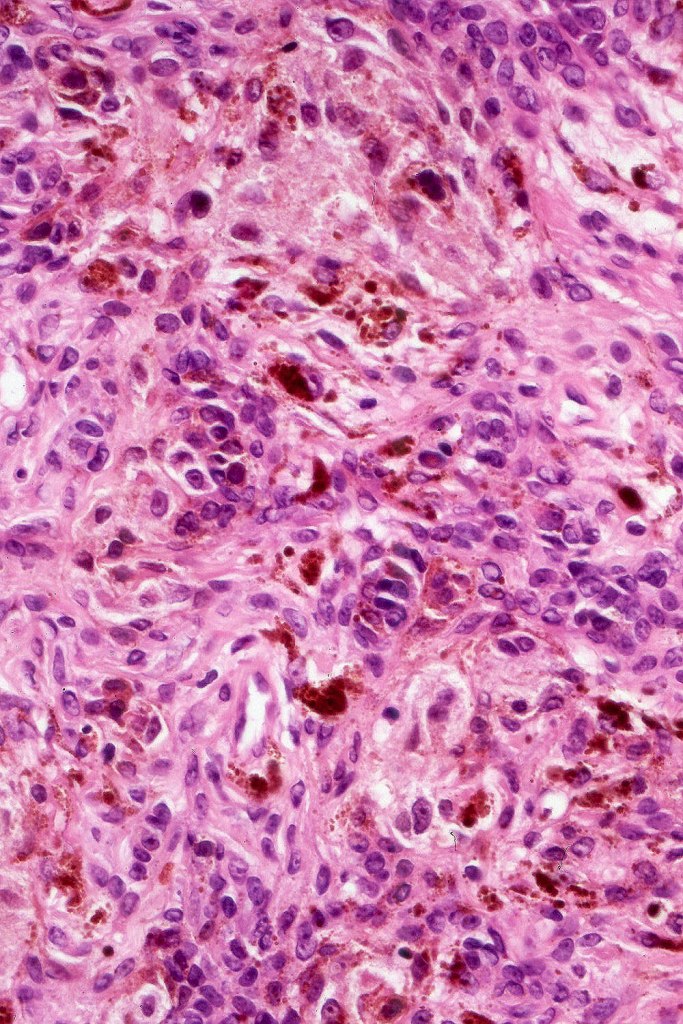
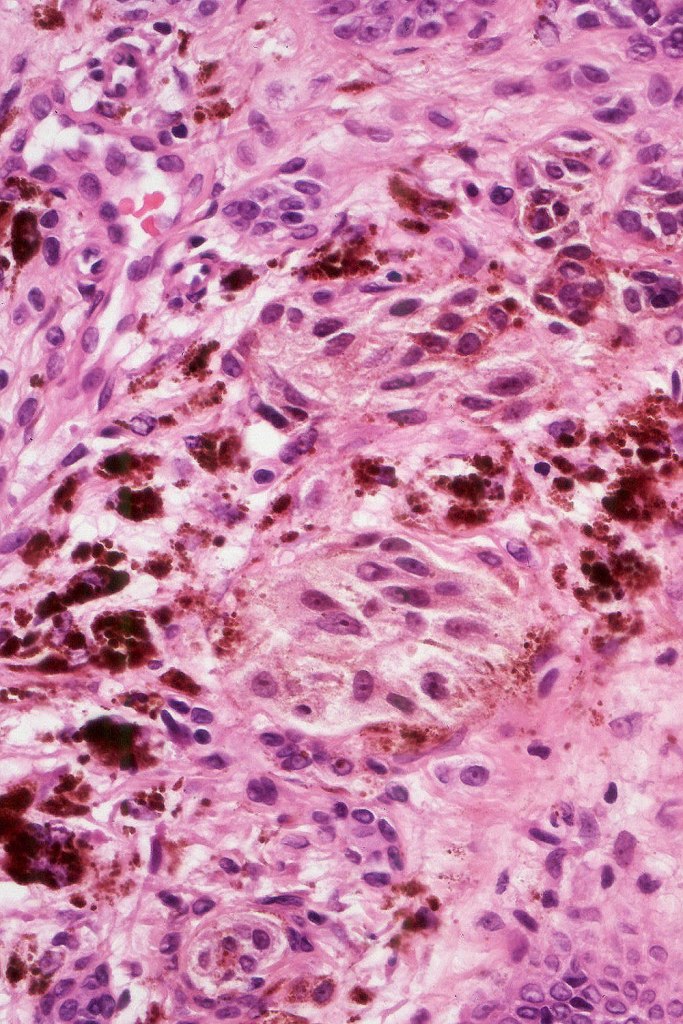
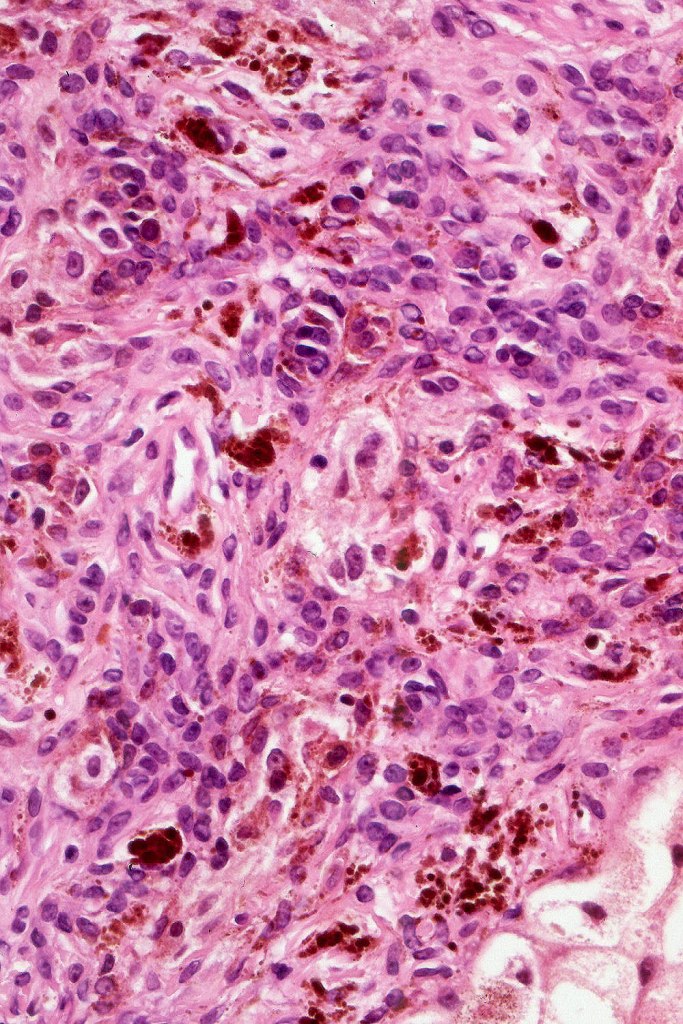
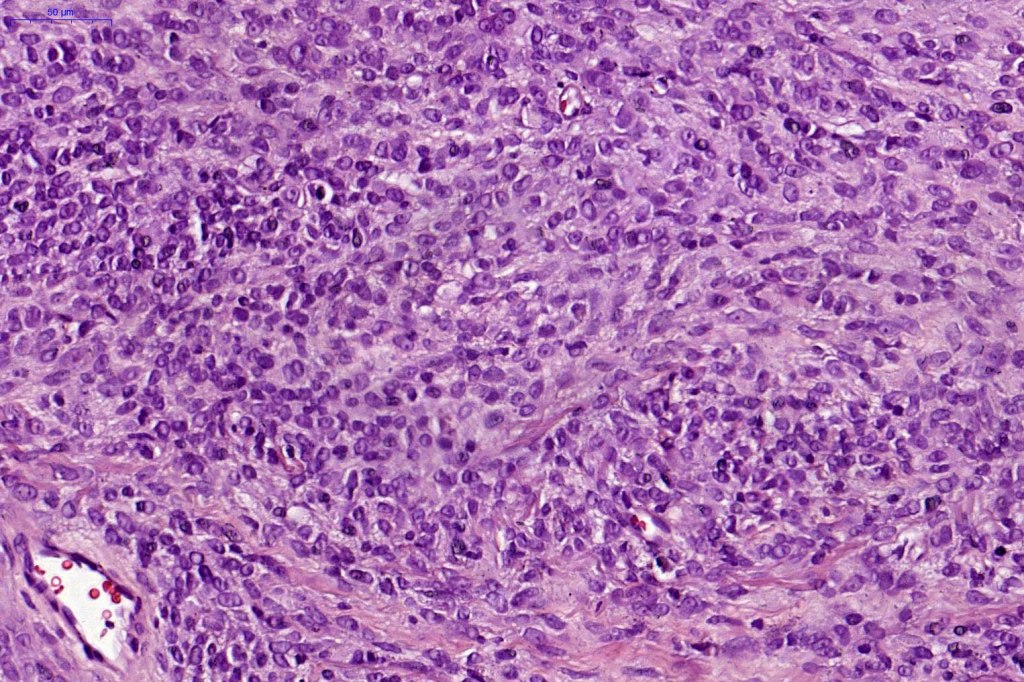
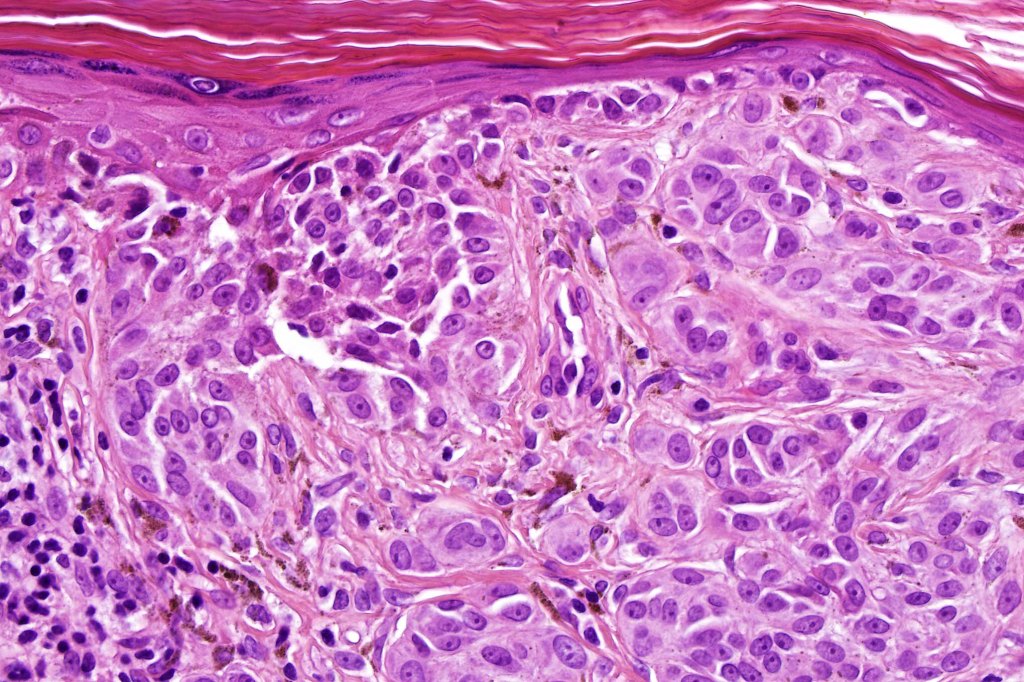
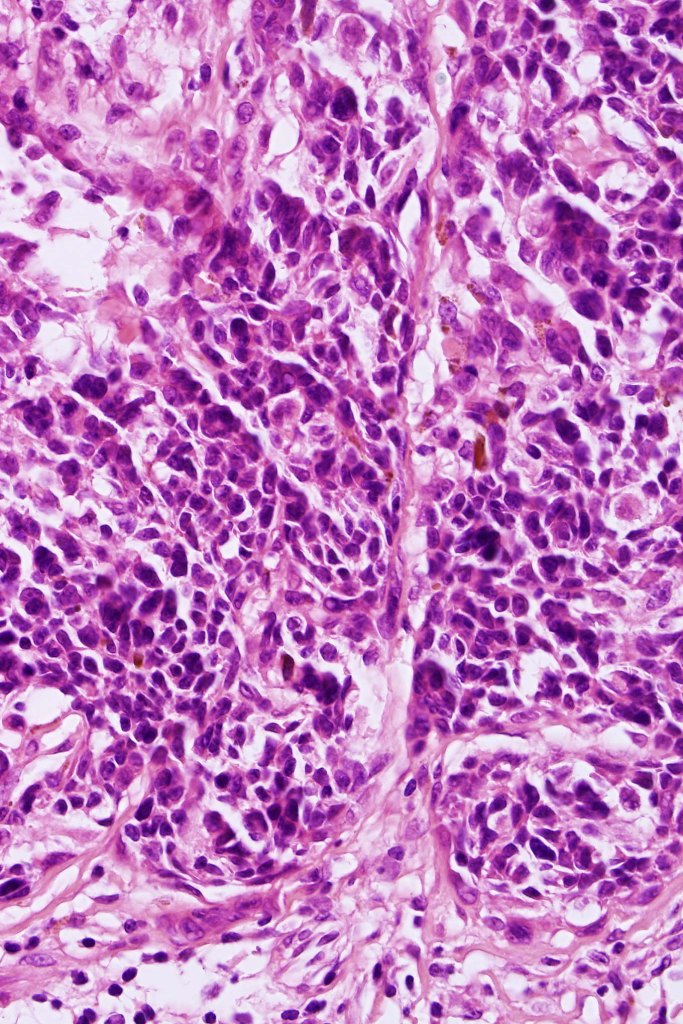
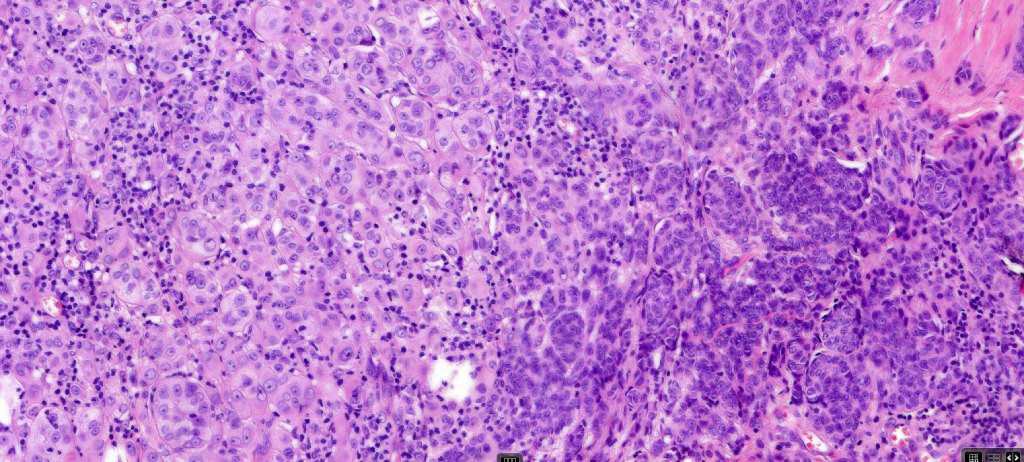

The term is used when 2 or more nevus subtypes are present in a a single lesion (phenotypic heterogeneity). It is mostly seen in commmon nevi, less often in congenital nevus, dysplastic nevus & Spitz nevus. The most commonly encountered combination is with deep penetrating nevus but combinations with blue & cellular blue nevi & pigmented epithelioid melanocytoma may also be encountered. BAP1-inactivated nevus is most commonly associated with a common nevus at the periphery. Combined nevus is of particular importance as the lesion often shows variegate pigmentation and is often irregular raising clinical suspicion of melanoma.


Combined common & deep penetrating nevus

Combined congenital & blue nevus (same case as the clinical photographs coursty of Dr. Antonina Kalmykova

Combined Spitz & common blue nevus

Combined common melanocytic nevus & BAP1-inactivated melanocytoma

Combined common melanocytic nevus and pigmented epithelioid melanocytoma











Leave a comment